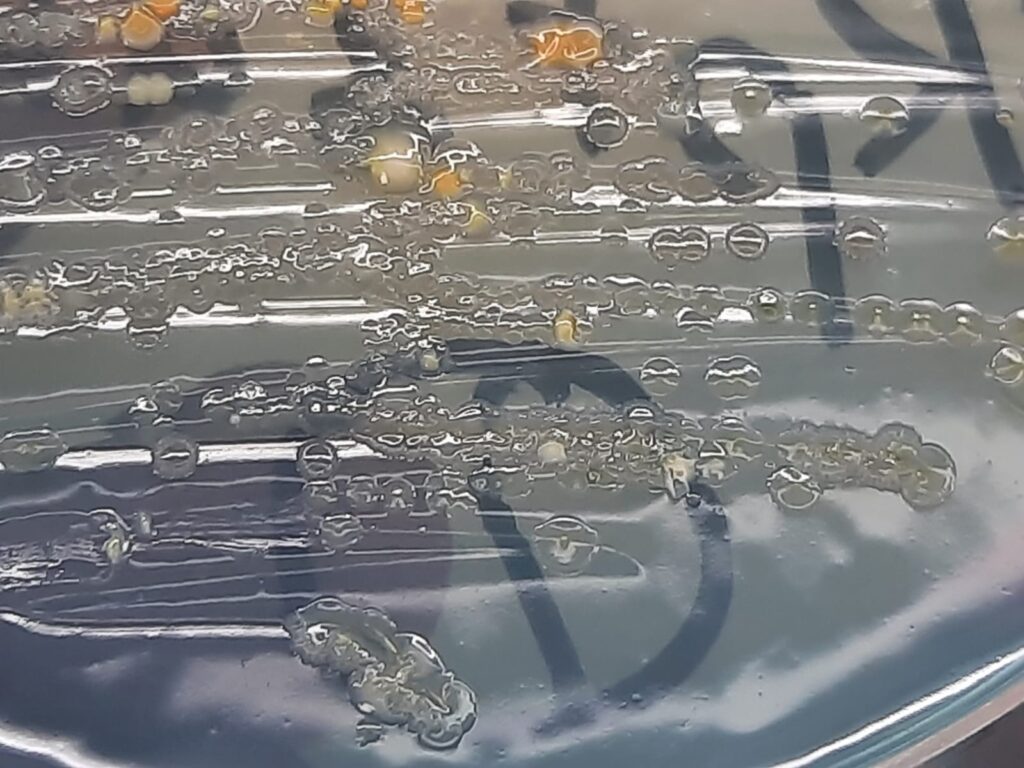
Acinetobacter haemolyticus growth on CLED agar

Introduction
Table of Contents
Acinetobacter haemolyticus is an aerobic, non-fermenting bacterium found in nature and hospital environments. It belongs to the Acinetobacter genus, frequently causing healthcare-associated infections. It is generally considered less virulent than Acinetobacter baumannii but is increasingly recognized in human infections.
Morphology
- Shape: Gram-negative coccobacilli
- Arrangement: Pairs or short chains
- Staining: Gram-negative
- Motility: Non-motile
- Colony Characteristics: Smooth, white to cream colonies on blood agar. It typically displays beta-hemolysis on blood agar, distinguishing it from non-hemolytic species.
Pathogenicity
- Opportunistic Nature: Primarily affects immunocompromised patients or those with invasive devices (ventilators, catheters).
- Infection Sites: It causes pneumonia (often ventilator-associated), bloodstream infections (BSIs), and infections in surgical or burn wounds.
- Virulence Factors: Adhesins (fimbriae) for attaching to surfaces and host cells, iron-acquisition systems, and the ability to form biofilms on medical equipment.
- Environmental Survival: Highly resilient; can survive for long periods in hospitals, contributing to persistent outbreaks.
Lab Diagnosis
- Specimens: The common specimens are blood, urine, sputum, and wound swabs.
- Gram Stain: Direct microscopic observation of Gram-negative coccobacilli.
- Culture: Grows readily on blood agar (showing hemolytic colonies) and MacConkey agar (non-lactose fermenting).
- Biochemical Tests: Oxidase-negative, catalase-positive, non-motile.
- Identification: Automated systems (e.g., VITEK 2 compact) or Matrix-Assisted Laser Desorption/Ionization-Time of Flight (MALDI-TOF) mass spectrometry (VITEK-MS).
Treatment
- Multidrug Resistance: Acinetobacter species, including Acinetobacter haemolyticus, are frequently resistant to multiple antibiotics.
- Treatment Options: Therapy is based on susceptibility testing, with carbapenems (meropenem, imipenem) commonly used, although resistance is rising.
- Alternative Agents: Colistin and tigecycline may be utilized for multidrug-resistant strains.
Prevention
- Infection Control: Strict adherence to hand hygiene by healthcare staff is critical.
- Environmental Cleaning: Enhanced cleaning and disinfection of patient rooms and equipment to eliminate environmental reservoirs.
- Infection Control Practices: Use of transmission-based precautions (wearing gloves or gowns) and cohorting patients with known infections.
Keynotes
- Acinetobacter haemolyticus is known for causing beta-hemolysis (hemolytic activity on blood agar).
- High resilience allows it to persist on dry surfaces.
- It is an increasingly important, yet sometimes overlooked, pathogen in nosocomial, especially ventilator-associated pneumonia (VAP).
- A major issue in treatment is the increasing emergence of carbapenem resistance.
Further Readings
- https://www.sciencedirect.com/topics/medicine-and-dentistry/acinetobacter
- https://en.wikipedia.org/wiki/Acinetobacter_haemolyticus
- https://www.uptodate.cn/contents/acinetobacter-infection-epidemiology-microbiology-pathogenesis-clinical-features-and-diagnosis/print
- https://clinicalgate.com/acinetobacter-stenotrophomonas-and-similar-organisms
- https://www.pathologyoutlines.com/topic/microbiologyacinetobacter.html
- https://www.sciencedirect.com/topics/pharmacology-toxicology-and-pharmaceutical-science/acinetobacter
- https://www.cdc.gov/acinetobacter/about/index.html
- https://microbenotes.com/acinetobacter-baumannii/
- https://www.infectiousdiseaseadvisor.com/ddi/acinetobacter
- https://www.sciencedirect.com/science/article/pii/S1198743X14626008
- https://www.researchgate.net/publication/49835614_Genotypic_and_phenotypic_characterization_of_the_Acinetobacter_calcoaceticus-Acinetobacter_baumannii_complex_with_the_proposal_of_Acinetobacter_pittii_sp_nov_formerly_Acinetobacter_genomic_species_3_a
- https://www.nature.com/articles/nrmicro1789
- https://www.sciencedirect.com/topics/agricultural-and-biological-sciences/acinetobacter
- https://pmc.ncbi.nlm.nih.gov/articles/PMC11925754
- https://elibrary.tucl.edu.np/items/2deb7edb-a5ed-4519-91d7-911e194f2234